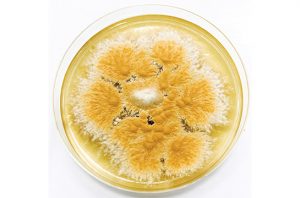

jamur


Jenis fungi makroskopis ada banyak, fungi-fungi tersebut biasanya mempunyai ukuran besar sehingga dapat terlihat secara langsung oleh mata. Salah satu fungi makroskopis yang paling terkenal adalah jamur Cookeina, spesies unik […]

Dermatofitosis adalah jenis penyakit yang disebabkan oleh kolonisasi jamur dermatofit yang menyerang jaringan keratin pada manusia. Spesies jamur yang dapat mengakibatkan infeksi kulit tersebut ada banyak, salah satunya Epidermophyton floccosum. […]

Histoplasma capsulatum merupakan sejenis fungi dimorfik yang dapat ditemukan di seluruh dunia, kecuali Arktika. Jamur ini berbiak di permukaan tanah yang mengandung tinja hewan. Sporanya dapat menyebar dan menyebabkan infeksi […]

Chlorophyllum rhacodes merupakan salah satu spesies jamur Agaricaceae, yang sebelumnya dimasukkan ke dalam genus Macrolepiota. Mereka berkerabat dengan spesies C. olivieri dan C. brunneum, ketiganya kemudian dijuluki sebagai kelompok jamur […]
Ringworm, dermatofitosis, atau biasa disebut kurap adalah penyakit kulit infeksius yang bisa menyerang hewan dan juga manusia. Penyakit ini disebabkan oleh jamur dermatofita, salah satu spesiesnya ialah Microsporum gypseum. Spesies […]


Di zaman modern seperti saat ini, tinta dibuat melalui proses pabrikasi dengan melibatkan berbagai macam senyawa. Namun, tahukah Anda bahwa tinta pernah dibuat menggunakan cairan hitam dari jamur? Inilah Coprinopsis […]

Cangkir peri kuning merupakan salah satu spesies jamur yang istimewa. Selain memiliki ukuran yang sangat kecil, warna fungi tersebut juga bisa mudah kita kenali. Bentuknya mirip seperti cangkir; tumbuh tanpa […]

Cyttaria darwinii atau lebih dikenal sebagai jamur Darwin (Darwin’s fungus), adalah spesies cendawan unik yang berasal dari famili Cyttariaceae. Kelompoknya cukup mudah kita kenali, sebab memiliki bentuk yang mirip seperti […]

Schizophyllum commune atau jamur grigit merupakan spesies jamur pelapuk yang tumbuh secara alami pada batang pohon maupun limbah kayu olahan. Mereka memiliki sifat yang ganas, sebab mampu menurunkan berat kayu […]

Popularitas jamur sebagai bahan alternatif ramah lingkungan kini tengah meroket. Itu semua karena jamur mengandung miselium yang terbukti dapat mengatasi polusi plastik, pencemaran lingkungan, hingga emisi gas rumah kaca. Selain […]

Panus neostrigosus merupakan spesies jamur yang unik, permukaannya memiliki bulu yang lebat dan berwarna keunguan. Meski terlihat “nyentrik,” jamur dari keluarga Polyporaceae ini nyatanya boleh kita makan, lho. Jamur Panus […]

Nama jamur kuping hitam atau Auricularia polytricha tentu sudah tidak asing lagi di telinga masyarakat. Jamur ini disinyalir mengandung berbagai senyawa aktif, yang mampu menjaga kebugaran tubuh serta menangkal beragam […]

Berbicara soal jamur bertopi, dua nama yang selalu muncul di benak masyarakat pasti jamur tiram atau shitake. Kendati demikian, nyatanya ada juga spesies jamur topi lain yang dapat dikonsumsi serta […]




















